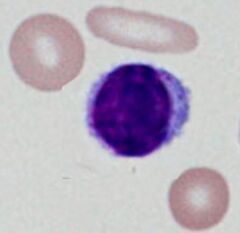

Pencil cells
From haematologyetc.co.uk
Derivation: little tail
Appearance
Long thin cells (roughly speaking they have at length more than 4 times their width); pencil cells are generally hypochromic. The cells have blunt rounded ends and no curvature and should not be confused with sickle cells
Image 1: Note the considerable elongation of the pencil form with a length at least four times that of its width and generally more "blunt-ended" than an elliptocyte. The cell is also hypochromic with pale colour and extensive central pallor. Generally, this erythrocyte form arises in the context of iron deficiency so will be accompanied by hyposchromic and microcytic cells.
Significance
These cells may be considered as variants of elliptocytes; however, the term “pencil cell” is generally applied to the hypochromic forms associated with iron deficiency. The pencil cell is often used to discriminate between iron deficiency and thalassaemia; however, the distinction is not absolute and pencil cells may occur in thalassaemia or anaemia of chronic disease (although less frequently).
Pathobiology
Pencil cells most frequently arise in the context of iron deficiency rather than elliptocytic disorders, however the precise mechanism for their formation is unclear.
Pitfalls
The cellular context is very important here – pencil cells should be hypochromic and be accompanied by hypochromic cells. Cells with greatly elongated form may arise in other conditions where there is very abnormal red cell morphology (e.g. a severe elliptocytosis or myelodysplasia), but these should not be described as pencil cells.
Causes
| Expected finding |
|---|
| Iron deficiency – increasing likely to be seen in more severe cases |
| May occur in |
| Thalassaemia (although much less common) |
| Anaemia of chronic disease (relatively uncommon) |
| As part of a specrum of features |
| In many disorders with defective red cell formation occasional very elongated cells may be seen, but the term is probably best restricted to hypochromic red cell forms |
Clinical Examples
Clinical Image 1: A single and well-formed pencil cell, note the greatly elongated form with a length that greatly exceeds the length. The remaining cells are clearly hypochromic with an expanded area of central pallor.
Clinical Image 1: 'This image contains very hypochromic erythrocytes with central pallor extending more than 50% of the cell area, they are also small (compare with the nucleus of the single erythrocyte). Two examples should be regarded as pencil cells; a further cell is significantly elliptocytic.